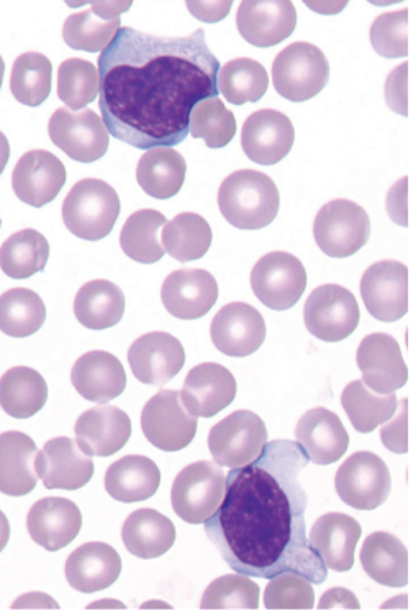

Colecistite acuta da EBV
Clinica Pediatrica, Università di Trieste
Indirizzo per corrispondenza: elenafavaretto93@gmail.com
Bambino di 7 anni, giunge in Pronto Soccorso (PS) per una storia di febbre elevata da 4 giorni, associata a dolore addominale ai quadranti destri e un unico episodio di vomito in assenza di alterazioni dellalvo. Allingresso in PS è in buone condizioni generali ma sofferente, con addome trattabile, dolorabile alla palpazione dei quadranti destri; a livello del faringe multiple lesioni aftose; alcune petecchie al palato.
Nel sospetto di appendicite si esegue unecografia delladdome (Figura 1), che però nega tale sospetto, ma evidenzia una colecisti a pareti inspessite senza calcoli nel lume con raccolta peri-colecistica settata di circa 6 mm; lieve splenomegalia.

Gli esami ematici mostrano una ipertransaminasemia (AST 393 U/l, ALT 777 U/l) con indici di colestasi aumentati (GGT 194 U/l, BT 2,73 mg/dl); all'emocromo leucopenia (3.530/ mmc) con neutropenia (800/mmc) e piastrinopenia (PLT 95.000). PCR aumentata (46,2 mg/l) con VES negativa.
Si decide pertanto di avviare una terapia antibiotica ad ampio spettro (piperacillina/tazobactam) di una colecistite acuta a eziologia presumibile batterica.
Il giorno successivo, alla luce dellemocromo con citopenia bilineare, si esegue striscio da sangue periferico con riscontro di linfomonocitosi e cellule di Downey (13%), in un quadro compatibile con mononucleosi infettiva (Figura 2).
In seguito al riscontro di valori molto elevati di IgM per EBV (IgM > 160, IgG negative) e alla presenza di 871 copie/ml del virus EBV su sangue, si conferma il sospetto diagnostico di colecistite acuta acalcolotica (ACC) in corso di infezione da EBV.
La colecistite acuta acalcolotica da EBV è una complicanza poco nota dellinfezione da EBV, con pochi casi descritti in letteratura nella popolazione pediatrica. Le patologie della colecisti sono di per sé rare in Pediatria, con circa 1,3 casi ogni 1.000 nella popolazione adulta. LACC comprende dal 5 al 10% di tutti i casi di colecistite acuta negli adulti. Nel bambino, si verifica spesso nel corso di infezioni (come sepsi, gastroenteriti severe, polmoniti, infezioni primitive da CMV, epatite A e altri germi). Nei casi descritti di ACC secondaria a EBV, levoluzione è tipicamente favorevole, con remissione completa del quadro clinico senza necessità di ricorrere alla chirurgia ma solo con la terapia di supporto.
Nel nostro caso, per persistenza della febbre e del dolore addominale a 48 ore dallingresso, è stata iniziata terapia steroidea con metilprednisolone a 2 mg/Kg ev per 5 giorni (con successivo scalo per os), ottenendo uno stabile sfebbramento a 12 ore dallavvio della terapia e una buona risposta sul dolore. Il piccolo è stato dimesso a una settimana dallingresso in reparto, con quadro clinico in sostanziale regressione.
